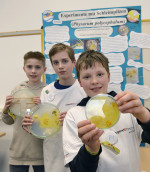

Neuwied im Zeichen der Wissenschaft: Jugend forscht begeistert
Am 22. Februar fand in Neuwied der 60. Regionalwettbewerb "Jugend forscht" bei der thyssenkrupp Rasselstein GmbH statt. Junge Talente präsentierten ihre innovativen Projekte und beeindruckten die Besucher mit ihrer Leidenschaft für Naturwissenschaften.

Neuwied. Am Samstag, dem 22. Februar, richtete die Thyssenkrupp Rasselstein GmbH den Regionalwettbewerb "Jugend forscht" und "Jugend forscht junior" aus. Die Veranstaltung fand im Bildungszentrum des Unternehmens statt und stand unter dem Motto "Macht aus Fragen Antworten". Ziel des Wettbewerbs ist es, Jugendliche für Mathematik, Informatik, Naturwissenschaften und Technik zu begeistern sowie Talente zu entdecken und zu fördern. Insgesamt stellten 48 junge Forscherinnen und Forscher ihre Arbeiten vor, wobei Biologie das am stärksten vertretene Fach war, gefolgt von Chemie, Geo- und Raumwissenschaften sowie Physik.
Am Vormittag wurden die Projekte von einer Fachjury begutachtet. Ab 14 Uhr hatten interessierte Besucher die Möglichkeit, die Arbeiten zu besichtigen und mit den jungen Wissenschaftlerinnen und Wissenschaftlern ins Gespräch zu kommen. Clarissa Odewald, Vorstandsvorsitzende der Thyssenkrupp Rasselstein GmbH, äußerte sich stolz: "Wir sind stolz darauf, jungen Forscherinnen und Forschern die Möglichkeit zu geben, ihre innovativen Ideen einem breiten Publikum vorzustellen. Es ist beeindruckend zu sehen, mit wie viel Begeisterung die Nachwuchsforscherinnen und -forscher an ihren Projekten arbeiten. Diese Leidenschaft wollen wir weiter fördern."
Während der anschließenden Feierstunde gab Hellen Ossmann, Wettbewerbsleiterin der Stiftung Jugend forscht e. V., die Gewinnerinnen und Gewinner bekannt. Die Sieger qualifizierten sich für den Landeswettbewerb im März und April 2025.
Tag der offenen Tür
Parallel zum Wettbewerb wurde ein Tag der offenen Tür veranstaltet, der von 10 bis 16 Uhr über 500 Besucher anzog. Diese erhielten Einblicke in die Werkstätten des Bildungszentrums und konnten sich über das Ausbildungsangebot informieren. "Die Jugendlichen konnten sich aktiv einbringen: Es wurde beispielsweise gelötet, Workshops zu naturwissenschaftlichen Berufen wurden angeboten, Steuerungen wurden programmiert", erklärte Claudia Tataranni, Leiterin Bildung und Personalentwicklung. Red
Lokales: Neuwied & Umgebung
Feedback: Hinweise an die Redaktion
| Alle Bilder (für eine größere Ansicht klicken Sie bitte auf eines der Bilder): |

|















